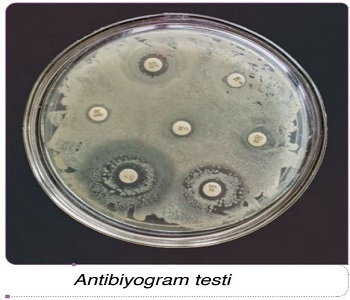

A. Varyasyon, Adaptasyon, Mutasyon, Doğal Seçilim ve Yapay Seçilim
► Bir canlı türünde bireyler arasında karakter bakımından önemli ölçüde faklılıklar bulunmaktadır. Yani tür içinde aynı genleri paylaşan bireyler birbirlerinden farklıdır. Bir popülasyon içinde gözlenebilen karakteristik farklılıklara varyasyon denir.
► Varyasyonlar genetik ve genetik olmayan olarak iki grupta incelenir.
► Genetik olan varyasyonlar; üreme hücrelerindeki mutasyon, mayoz ve eşeyli üreme ile gerçekleşirken genetik olmayan varyasyonlar ise sıcaklık, ışık miktarı, beslenme, kimyasal maddeler ve mekanik etkiler gibi çevresel faktörlerle ortaya çıkan modifikasyonlardır.
► Çevresel şartlar devamlı değişim içindedir. Bu şartlar kendine uyumlu özelliklere sahip bireylerin yaşama ve üreme şanslarını artırırken uyum gösteremeyen bireylerin elenmesine neden olur. Bu nedenle gelecek nesiller, çevresel şartlara uyumlu özellikleri taşıyan bireylerden oluşur.
► Türler, nesilden nesile geometrik dizi şeklinde artma eğilimi gösterir.
► Canlılar yaşamak için gerekli besin, su, ışık ve diğer çevresel faktörler bakımından rekabet hâlinde olup bu rekabetle başarılı olan bireyler yaşarken diğerleri elenir.
► Canlılarda sayıca artma eğilimi olduğu hâlde, bir türdeki birey sayısı bu rekabetten dolayı hemen hemen sabit kalır.
► Her türün bireyleri arasında genetik farklılıklar gerçekleşebilir ve yeni kalıtsal varyasyonlar gözlenebilir. Sonuçta bazı kalıtsal varyasyonlara sahip bireylerin belirli bir çevrede yaşama şansı artarken diğer bireyler elenir.
► Çevre şartlarına uygun kalıtsal varyasyonlara sahip olan bireylerin yaşama şansı, diğer bireylere oranla daha fazla olacaktır.
► Bu durumun sonucu olarak çevreye uygun varyasyonlara sahip bireylerin sayısında artma, diğer bireylerin sayısında ise bir azalma beklenebilir.
► Aynı türün bireyleri arasındaki varyasyonlar, değişik çevrelerde, farklı şekillerde seçilime uğrar.

► Bu seçilim sonucunda zamanla nesiller arasındaki farklar daha belirgin hâle gelerek bir türden, yeni türler gelişir.
► Belirli kalıtsal özelliklere sahip olan bireylerin, değişen çevre koşullarında, bu özelliklerinden dolayı diğer bireylere göre yaşama ve üreme şanslarının daha yüksek olmasına doğal seçilim denir.
► Doğal seçilim, çevreye uygun varyasyonlara sahip bireylerin yaşayıp diğerlerinin elenmesidir. Bu durum, canlıların çevreye uyum sağlamalarına yani adaptasyona neden olur.
► Adaptasyon, canlı türlerinin yaşama ve üreme şansını artıran kalıtsal özelliklerdir.
► Örneğin DDT, böcek ilacıdır. Ancak DDT’nin ilk kullanıldığı bölgede hemen hemen bütün sinekler, ilacın etkisiyle ölmüştür. Bununla beraber pek az sayıda birey, sahip olduğu varyasyonlardan dolayı DDT’den zarar görmemiştir. Bu bireyler DDT’li ortamlarda yaşama ve üreme şanslarını artırdıklarından o bölgede dayanıklı bireylerin sayısı sonraki yıllarda artmıştır. İlerleyen zamanlarda ise DDT’ye dayanıklı sinekler yaşamaya devam etmiştir.
► Dayanıklı varyasyona sahip sinekler, başlangıçta çok az sayıda olduğu hâlde DDT kullanılan bölgelerde sinek topluluklarının hemen hemen tümünü meydana getirmiştir. DDT’nin kullanılması, dayanıksız sinekler yerine dayanıklı sineklerin yaygın hâle gelmesini sağlayan seçici bir faktör olmuştur. Yani DDT, bir çevre faktörü olarak ortaya çıkmış, seçilime sebep olmuştur.
► Bir türün bireyleri arasındaki kalıtsal varyasyonlar üzerinde de biraz durmalıyız. Çünkü doğal seçilimin işlemesi için her şeyden önce aynı türe ait bireyler arasında farklı kalıtsal özellikler taşıyan bireylerin bulunması gerekir
► Bir canlının sahip olduğu bütün kalıtsal özelliklerin eşey hücreleri yoluyla nesilden nesile geçtiğini biliyoruz. Eşey hücrelerinin çekirdeklerindeki kalıtımı aktaran maddenin kimyasal yapısında radyasyon, X ışınları, UV ışınlar, kimyasal maddeler, virüsler gibi sebeplerle değişiklikler meydana gelebilir. Bu olaya mutasyon denir.

► Eşey hücrelerinin kalıtım materyalindeki mutasyonlar, yeni nesildeki bireyler arasında farklı özellikler oluşturabilir.
► Doğal seçilim, bu varyasyonları, farklı çevrelerde o çevrenin şartlarına göre değişik şekillerde seçerek değişime yön verir ve yeni türlerin gelişmesine yol açar.
► Canlılardaki değişimin, belirli bir türde, çok uzun zaman boyunca eklenen veya çıkarılan birçok küçük adaptasyon sonucu oluştuğu düşünülebilir.
► Sonunda bir grup birey, aynı türün diğer bireylerinden o derece farklı hâle gelir ki diğer bireylerle verimli döller oluşturamaz ve bu bireyler yeni bir tür olarak kabul edilir.
B. Bakterilerin Antibiyotiklere Karşı Direnç Geliştirmesi
► Direnç kelimesi, dayanma ve karşı koyma gücü anlamına gelmektedir.
► Antibiyotik direnci, antibiyotik denilen maddeye dayanabilmek ya da karşı koyabilmek ve antibiyotiklerden etkilenmemektir. Küf mantarları ve bazı canlılar tarafından üretilen antibiyotik denilen penisilin, streptomisin, teramisin gibi kimyasal maddeler, insanlarda hastalık yapan bakteri türlerinin yok edilmesi için kullanılmaktadır.
► Ancak bakteri türlerindeki kalıtsal varyasyonlar, antibiyotiklere karşı direncin oluşmasına neden olmaktadır.
► Antibiyotik direnci, bir bakterinin antibiyotiklerin etkilerine karşı durabilme yeteneğidir. Özellikle penisilinin keşfinden sonra bakteriler antibiyotiklere karşı hızla direnç geliştirmeye başlamıştır.
Peki, bu direnç nasıl oluşur? Yaşamın her alanında gördüğümüz bakteriler, antibiyotik direncini temelde 4 ana mekanizmayla oluşturur:
• Bakterinin hücre zarı; antibiyotikleri içeri almayan, geçirgenliği olmayan bir bariyer oluşturur.
• Bakteri, antibiyotiklerin bağlandığı reseptörleri değiştirir. Böylece bakteri üzerinde bağlanacak yer bulamayan antibiyotik, o bakteriye karşı işlevsiz kalır.
• Bakteri, antibiyotik ona zarar vermeden önce antibiyotiği işlevsiz kılacak enzimler üretir.
• Antibiyotik, bakteri tarafından özelleşmiş mekanizmalarıyla hücre dışına atılır.
► Antibiyotik direncine sahip bakteriler antibiyotik varlığında, dirençli olmayan bakterilere göre avantaj sağlar.
► Bunun sonucunda, belirli bir süre sonra ortamdaki bakterilerin çoğu o antibiyotiklere karşı doğal olarak seçilerek direnç sahibi olur.
► Ayrıca, bakteriler dirence neden olan genetik özelliklerini farklı bakteri türlerine de aktarabilir.
► Bu durum antibiyotik direncinin bakteriler arasında yaygınlaşmasına sebep olur.
► Bilim insanları dirençli bakterileri yok etmek için yeni moleküller üzerinde çalışsalar da elde edilen veriler, bakterilerdeki antibiyotik direncinin hızla arttığını ve dirençli bakterilerin yakın gelecekte çok büyük sorunlara neden olacağını göstermektedir.
► Öyle ki yakın gelecekte enfeksiyon hastalıklarının tedavisinde antibiyotikler tamamen etkisiz hâle gelebilir ve basit yara enfeksiyonları bile ölümle sonuçlanabilir. Bakterilerin hangi antibiyotik çeşidine direnç gösterdiklerini anlamak için yapılan testlere antibiyogram testi adı verilir.
► Bu test sayesinde uygun antibiyotik kullanılır. Antibiyotik direnci oluşumunu azaltmak için hekimlerin verdiği reçete bilgilerine göre ve belirtilen miktarlarda tüketmeliyiz. Ayrıca doktor bilgisi dışında antibiyotik tüketilmemelidir.
C. Herbisit ve Pestisitlerin İnsan ve Çevre Üzerine Etkileri
► Pestisit terimi; insektisit (böcek öldürücü), herbisit (yabani ot öldürücü), fungusit (mantar öldürücü), rodentisit (kemirgen öldürücü) vb. şeklinde sınıflandırılan kimyasal maddelerin tümünü kapsamaktadır.
► Pestisitlerin kullanımı çok eski tarihlere dayanmaktadır. MÖ 1500’lere ait bir papirüs üzerinde bit, pire ve eşek arılarına karşı insektisitlerin hazırlanışına dair kayıtlar bulunmuştur.
► 19. yy.da zararlılara karşı inorganik pestisitler kullanılmış, 1940’lardan sonra pestisit üretiminde organik kimyadan faydalanılmış, DDT, insektisit ve herbisitler keşfedilmiştir.
► Bugüne kadar 6000 kadar sentetik bileşik patent almasına karşın, bunlardan 600 kadarı ticari kullanım imkânı bulmuştur.
► Ülkemizde tarımı yapılan kültür bitkileri, sayıları 200’ü aşan hastalığın ve zararlının tehdidi altındadır. Bunlarla etkili şekilde mücadele edilmediği için toplam ürünün yaklaşık 1/3’ü kayba uğramaktadır. Bu kayıpların önlenmesi bakımından pestisitlerin daha uzun yıllar büyük bir kullanım potansiyeline sahip olacağı kuşkusuzdur.
► Pestisit kullanımında en yoğun kullanılan gruplar sırasıyla herbisitler, insektisitler ve fungusitlerdir.
► Bununla beraber, yoğun ve bilinçsiz pestisit kullanımının sonucunda gıdalarda, toprak, su ve havada kullanılan pestisitin kendisi ya da dönüşüm ürünleri kalabilmektedir.
► Pestisit kalıntılarının önemi, 1948 ve 1951 yıllarında insan vücudunda organik klorlu pestisit kalıntılarının bulunmasıyla anlaşılmıştır. Pestisitlerin bazıları zehirlilik açısından bir zarar oluşturmazken bazılarının kanserojen, sinir sistemini etkileyici hatta mutasyon oluşturucu etkileri saptanmıştır.
► Pestisit kalıntılarının en önemli kaynağı gıdalardır. Bu nedenle 1960 yılında FAO (Gıda Tarım Örgütü) ve WHO (Dünya Sağlık Örgütü) “Pestisit Kalıntıları Kodeks Komitesi”ni kurmuş ve bu komitenin çalışmaları sonucu konu ile ilgili tanımlamalar yapılmış, bilimsel araştırma verilerine dayanılarak gıdalarda bulunmasına izin verilen maksimum kalıntı değerleri saptanmıştır.
► Ülkemizde de tarımsal ürünlerde kullanılan pestisitlerin gıdalarda bulunması müsaade edilebilir maksimum miktarları, ürün ve ilaç bazında belirlenmiştir. Bu bilgilere Tarım ve Orman Bakanlığının genel ağ sayfasından kolaylıkla ulaşmak mümkündür.
Pestisitlere Karşı Dayanıklılık Oluşumu
► Mücadelede kullanılan pestisitlere karşı zararlıların dayanıklılık kazandıkları bilinmektedir.
► Dayanıklılığın pratikteki anlamı, hastalıkların ve zararlıların daha önce kendilerine karşı başarıyla uygulanan zehirli maddelerden artık etkilenmedikleridir.
► Tarımsal ürün zararlılarında meydana gelen çeşitli tipteki dayanıklılıklar sonucunda pestisitin etkinliğindeki azalmayı aşmak için daha yüksek dozlarda uygulama gerekmekte, bu da hem maliyetin artmasına ve ürün veriminde azalmalara yol açmakta hem de üründe ve çevrede kalıntı miktarını ve kirliliği artırmaktadır.
► Bu nedenle pestisit kullanımı engellenmeli, daha çok biyolojik mücadele yöntemi tercih edilmelidir.

► İnsanlar, tarih boyunca belirli özelliklere sahip hayvanların ve bitkilerin kendi aralarında döllendirilmesiyle istenen özellikteki yavruların doğma şansının artırılabileceğini biliyorlardı.
► Bir türe ait canlılarda insanlar tarafından istenilen bazı özelliklerin seçilmesi ve kontrollü olarak yetiştirilmesine yapay seçilim denir.
► Bilim insanları, konu üzerinde çok uzun yıllar çalışmış ve pek çok evcilleştirme işlemi gerçekleştirmişlerdir.
► Yapay seçilim, canlılarda istenilen özelliklerin insanlar tarafından seçilip üretilmesidir.
► Yapay seçilimin birçok uygulaması vardır. Örneğin günümüzdeki bütün evcil köpekler, Canis lupus familiaris (Kanis lupus familiaris) ve Canis lupus dingo (Kanis lupus dingo) denilen iki alt türe aittir. Bunların tümü, vahşi kurt olarak bildiğimiz Canis lupus türünün alt türleridir. Günümüzde görülen çok farklı köpek çeşitliliği, insanların seçimleri nedeniyle ortaya çıkmıştır.

► Yabani lahananın (Brassica oleracea-brassika olarasea) yapay seçilimi sonucu, insanlar bu lahananın farklı özelliklerini seçmiş ve brokoli, karnabahar, Brüksel lahanası, karalahana, kıvırcık lahana, yer lahanası gibi çeşitlerini elde etmiştir. İnsanlar tarafından yapay olarak seçilmiş ve yetiştirilmiş hayvan ve bitki türleri kültür olarak adlandırılır.

► Yediğimiz etler, genellikle en kaliteli ete sahip inek, koyun vb. hayvanların, sürekli kaliteli ete sahip olan diğer bireylerle çiftleştirilmesi sonucu elde edilmektedir.
► Dünyanın en ünlü atlarından olan İngiliz atları, Arap atlarının sürekli olarak en hızlı ve güçlülerinin yapay olarak seçilmesi sonucunda elde edilmiştir. Bu seçilim, günümüzde de yapay olarak sürdürülmektedir.
► Yapay seçilimin pek çok kullanım alanını görebiliyoruz. Örneğin yapay seçilim, bakteriler arasında da uygulanarak bazı ilaçlar üretilebilmektedir.
► Yapay seçilim, tür içi çeşitliliği azaltır. Bu nedenle de yapay seçilimin hastalıklara, salgınlara ve bazı zayıf özelliklere sebep olabilen olumsuz etkileri de görülebilir.
► Örneğin sürekli bol süt veya et vermesi yönünde seçilim yapılan bir canlının, doğada serbest bırakıldığında yaşamak için zorluklar çektiği görülür. Bu nedenle yapay seçilimin uygulandığı yerlerde, çok ciddi bir bakım ve takip gerekir.
Konuya Ait Çıkmış Sorular
Aynı türün bireyleri arasında görülen farklılıklar iki biçimde olabilir. Bunlardan modifikasyon, çevre koşullarının etkisiyle ortaya çıkar ve kalıtsal değildir. Varyasyon ise bireylerin kalıtsal yapısındaki farklılıklardan kaynaklanır.
Buna göre, modifikasyon ve varyasyonla ilgili,
1. Bütünüyle siyah renkli bir dişi kedinin bir seferde doğan üç yavrusundan birinin beyaz, birinin gri, birinin de siyah-beyaz benekli olması
2. Doğduklarında birbirinden ayrılarak farklı ortamlarda yetiştirilen tek yumurta ikizlerinin, boylarının farklı olması
3. Bir çuhaçiçeği türünün 30 oC tan düşük sıcaklıkta gelişmesi durumunda, çiçeklerinin kırmızı renkli; 30 oC tan yüksek sıcaklıkta gelişmesi durumunda ise beyaz renkli olması
4. Renklenmeleri (pigmentasyonu) normal olan ana-babadan, albino özellikte çocuğun olması
Örnekleri aşağıdakilerin hangisinde doğru olarak gruplandırılmıştır?
(2002-Öğrenci Seçme Sınavı (ÖSS))
A. Modifikasyon → 3 Varyasyon → 1, 2, 4Doğru Cevap İçin Tıklayınız...
I. Adaptasyon
II. Mutasyon
III. Kalıtsal varyasyon
Bir populasyondaki bireyler, yukarıdakilerden hangilerini “doğal seçilim”le kazanır?
(2006-Öğrenci Seçme Sınavı (ÖSS))
A. Yalnız IDoğru Cevap İçin Tıklayınız...
Farklı organizma türleri evrimsel süreçte benzer çevre koşullarının etkisiyle benzer uyumsal özellikler kazanırlar
Aşağıdakilerden hangisi bu duruma bir örnek değildir?
(2011-Lisans Yerleştirme Sınavı (LYS))
A. Balıkların ve yunusların mekik şeklinde gövdeye sahip olmasıDoğru Cevap İçin Tıklayınız...
Elektrik üretiminde kullanılan
I. Termik santral,
II. Güneş,
III. Rüzgâr
Enerji kaynaklarından hangileri asit yağmurlarının oluşmasına neden olur?
(MEBİ 02.12.2024 TYT Deneme Sınavı)
A. Yalnız IDoğru Cevap İçin Tıklayınız...
Bir ekosistemde, 50 yıl öncesine göre şu durumlar gözleniyor:
- Bitkilerin yaklaşık 1 hafta erken çiçeklendiği
- Kuşların ortalama 9 gün erken kuluçkaya yattığı
- Kurbağaların yaklaşık 7 hafta erken çiftleştiği
Ekosistemde gerçekleşen bu durumun temel nedeni aşağıdakilerden hangisidir?
(2010-Yükseköğretime Geçiş Sınavı (YGS))
A. İklim değişikliğiDoğru Cevap İçin Tıklayınız...
Canlılarda görülen,
I. Çevresel faktörlerin, bazı genlerin işleyişini değiştirmesi
II. Kalıtsal materyalde, ani bazı değişikliklerin meydana gelmesi
III. Eşeyli çoğalma ile, genlerin yeni kombinasyonlarının oluşturulması
Olaylarından hangileri, modifikasyonu tam ve doğru olarak açıklar?
(2015-Lisans Yerleştirme Sınavı (LYS))
A. Yalnız IDoğru Cevap İçin Tıklayınız...
Aşağıdakilerin hangisinde, ortaya çıkmış olan fenotipik farklılık kalıtsaldır?
(2017-Lisans Yerleştirme Sınavı (LYS))
A. Van kedisinin gözlerinin birbirinden farklı renkte olmasıDoğru Cevap İçin Tıklayınız...
Çocuklar bütün kalıtsal özelliklerini anne ve babalarından aldıkları halde, anne ve babadan oluşan kardeşlerin, kalıtsal materyalleri oldukça farklı olabilmektedir.
Bu durumun nedeni, aşağıda belirtilenlerden hangisidir?
(2011-Lisans Yerleştirme Sınavı (LYS))
A. Eşey hücrelerinin mayoz bölünme sonucunda meydana gelmesiDoğru Cevap İçin Tıklayınız...
Bir bilim insanı, insan genomunda meydana gelen mutasyonların oluşum hızı ve miktarını araştırmak için Y kromozomunu seçmiştir.
I. Cinsiyetin, Y kromozomunun varlığına veya yokluğuna bağlı olarak belirlenmesi
II. Y kromozomunun babadan erkek çocuğa geçmesi
III. Y kromozomunun X'e homolog olmayan parçasındaki genlerin birinci dölde fenotipte etkisini göstermesi
Y kromozomuna ait yukarıdaki özelliklerden hangileri, bu araştırma için Y kromozomunun seçilmesinde etkili olmuştur?
(2007-Öğrenci Seçme Sınavı (ÖSS))
A. Yalnız IDoğru Cevap İçin Tıklayınız...
Evrimleşme sürecinde, aşağıdakilerin hangisinin meydana gelmesinde doğal seçilimin katkısı yoktur?
(2007-Öğrenci Seçme Sınavı (ÖSS))
A. Canlı türlerinin değişik ortamlara uyumunun sağlanmasındaDoğru Cevap İçin Tıklayınız...
Farklı organizma türleri evrimsel süreçte benzer çevre koşullarının etkisiyle benzer uyumsal özellikler kazanırlar.
Aşağıdakilerden hangisi bu duruma bir örnek değildir?
(2002-Öğrenci Seçme Sınavı (ÖSS))
A. Balıkların ve yunusların mekik şeklinde gövdeye sahip olmasıDoğru Cevap İçin Tıklayınız...
Deney 1: Kirliliğin olmadığı, bu nedenle de açık renkli likenlerin ağaç gövdelerini kapladığı kırsal bir ekosistemdeki doğal kelebek popülasyonunun %95'inin beyaz renkli olduğu saptanıyor. Bu ortama kanat rengi siyah ve beyaz olan kelebeklerden eşit sayıda bırakıldığında kuşların yakaladığı kelebeklerin %86'sının siyah renkli, %14'ünün beyaz renkli olduğu görülüyor.
Deney 2: Endüstriyel kirlilik nedeniyle likenlerin gelişemediği ve ağaç gövdelerinin fabrika bacalarından çıkan isle koyulaştığı şehre yakın bir ekosistemde ise aynı türe ait kelebek popülasyonunun %85'inin siyah renkli olduğu saptanıyor. Bu ortama kanat rengi siyah ve beyaz olan kelebeklerden eşit sayıda bırakıldığında, kuşların yakaladığı kelebeklerin %80'inin beyaz renkli, %20'sinin siyah renkli olduğu görülüyor.
Bu deneylerle ilgili olarak,
I. Çevre koşullarındaki değişiklikler kanat renginden sorumlu gende mutasyona yol açmıştır.
II. Kirliliğin olmadığı ortamdaki kelebek popülasyonunun yaklaşık %5'inin siyah kanatlı olması türün kalıtsal özelliğidir.
III. Popülasyonlarda farklı kanat rengine sahip bireylerin oranının değişmesinin nedeni, doğal seçilimdir.
Yargılarından hangileri doğrudur?
(2012-Yükseköğretime Geçiş Sınavı (YGS))
A. Yalnız IDoğru Cevap İçin Tıklayınız...
Canlılarda, tür içindeki kalıtsal varyasyonların (çeşitliliğin) ortaya çıkmasında, aşağıda verilen durumlardan hangisi etkili değildir?
(2000-Öğrenci Seçme Sınavı (ÖSS))
A. Doğal seleksiyonun olmasıDoğru Cevap İçin Tıklayınız...
Bir popülasyondaki bireyler,
I. Adaptasyon
II. Mutasyon
III. Kalıtsal varyasyon
Şeklindeki durumlardan hangilerini, "doğal seçilim" yoluyla kazanır?
(2018-YKS-Alan Yeterlilik Testleri (AYT))
A. Yalnız IDoğru Cevap İçin Tıklayınız...
1950'li yıllarda bir bölgede, DDT gibi tarım ilaçlarının kullanılmaya başlamasından hemen sonra, tarım ürünlerinden yüksek verim alınmış ve ayrıca, bölgede yaygın olan sıtma hastalığı hemen hemen ortadan kalkmıştır. Ancak sonraki 20 yıl içinde bölgede tarım ilaçları giderek daha fazla kullanıldığı halde, tarım zararlıları ve sıtma hastalığı artmaya başlamıştır.
Kullanılan tarım ilaçları,
I. Tarım zararlılarının direnç kazanması
II. Yararlı böceklerin yok olması
III. Tatlısu balıkları ve kurbağaların azalması
Değişikliklerinden hangilerine neden olduğu için 20 yıl sonraki bu durum ortaya çıkmıştır?
(2020-YKS-Alan Yeterlilik Testleri (AYT))
A. Yalnız IDoğru Cevap İçin Tıklayınız...
Aşağıdaki grafikler, yıllık yağış ortalamalarında farklılıklar saptanan bir ekosistemde, bir bitki popülasyonunun K, L, M, N, P ve R varyasyonlarının 1, 2 ve 3.yıllardaki dağılımını göstermektedir.

Buna göre, aşağıdaki yargılardan hangisi yanlıştır?
(2006-Öğrenci Seçme Sınavı (ÖSS))
A. Popülasyonun devamlılığı, varyasyonların birey sayılarının aynı kalmasıyla sağlanmıştır.Doğru Cevap İçin Tıklayınız...
Evrimleşme sürecinde, aşağıdakilerin hangisinin meydana gelmesinde doğal seçilimin katkısı yoktur?
(2012-Lisans Yerleştirme Sınavı-2 (LYS2))
A. Canlı türlerinin değişik ortamlara uyumunun sağlanmasındaDoğru Cevap İçin Tıklayınız...

Yukarıdaki grafikte numaralanmış eğrilerden hangisi, besin kaynakları sınırlı olan bir gölde bulunan ve yoğunluğu giderek artan bir balık popülasyonunda besin bulmak için bir bireyin harcadığı enerji miktarındaki değişimi göstermektedir?
(2012-Lisans Yerleştirme Sınavı-2 (LYS2))
A. 1Doğru Cevap İçin Tıklayınız...
Yapay seçilimde, istenilen özellikleri taşıyan canlıların seçilerek çoğaltılması amaçlanır. Bu bağlamda, hem geleneksel ıslah hem de genetik mühendisi alanındaki çalışmalardan yararlanılabilir.
Aşağıdakilerden hangisi "yapay seçilim” uygulamalarına örnek değildir?
(2019-YKS-Alan Yeterlilik Testleri (AYT))
A. Herbisitlere dirençli kültür bitkilerinin üretilmesiDoğru Cevap İçin Tıklayınız...
Bir canlı organızmayı transgenik olarak tanımlayabilmek için bu organizmanın aşağıdaki özelliklerden hangisine sahip olması gerekir?
(2018-YKS-Alan Yeterlilik Testleri (AYT))
A. Yapay yöntemlerle mutasyona uğratılmış olmasıDoğru Cevap İçin Tıklayınız...
Konu İle İlgili Sorular
Aşağıda canlılarda tür içi kalıtsal çeşitliliğe neden olan bazı olaylar verilmiştir.
Verilen olaylardan hangisi eşeysiz üreme sırasında kalıtsal çeşitliliğe neden olur?
A. Mutasyonların oluşmasıDoğru Cevap İçin Tıklayınız...
Doğru Cevap: A
Açıklaması:
📘 Konu Kısa Bilgi: Bu soru, kalıtsal çeşitliliğe neden olan mekanizmalar konusunu ölçen bir bilgi ve analiz sorusudur. Kalıtsal çeşitlilik, tür içindeki bireylerin genetik farklılıklarını ifade eder.
Eşeyli üreme sırasında kalıtsal çeşitlilik; → Mayoz bölünme, → Crossing over, → Döllenme, → Homolog kromozom ayrılması gibi olaylarla oluşur.
Ancak eşeysiz üreme, genetik olarak birebir aynı yavrular oluşturur. Buna rağmen, mutasyonlar eşeysiz üreme yapan canlılarda da kalıtsal çeşitliliğe neden olabilir.
🔍 Şık Analizi:
A) Mutasyonların oluşması ✅ → Doğru cevap. → Mutasyon, DNA’daki ani ve kalıcı değişikliktir. → Eşeysiz üreyen canlıda bile mutasyon olursa, bu yavruya kalıtılır → çeşitlilik oluşur.
B) Crossing over olayları ❌ → Bu olay sadece mayoz bölünmede görülür. → Eşeysiz üreme mitoz ile olur → crossing over gerçekleşmez.
C) Homolog kromozom ayrılması ❌ → Yine sadece mayoz bölünmeye özgüdür. → Eşeysiz üreme sürecinde bu olay gerçekleşmez.
D) Konjugasyon ❌ → Bakterilerde görülür ama bu eşeyli üreme değildir, sadece genetik materyal aktarımıdır. → Konjugasyon, çeşitlilik oluşturur ama eşeysiz üreme sayılmaz.
E) Döllenmenin yapılması ❌ → Sadece eşeyli üreme sürecine aittir. → Eşeysiz üreyen canlılarda döllenme olmaz.
Mutasyonların etkileri, en kolay mikroorganizmalarda (bakteriler gibi) incelenebilir.
Bu canlılarda mutasyon etkisinin daha kolay incelenmesi aşağıdakilerden hangisi ile açıklanabilir?
A. Bakterilerde gen sayısının normalden çok az olmasıDoğru Cevap İçin Tıklayınız...
Doğru Cevap: C
Açıklaması:
📘 Soru Hakkında Kısa Bilgi: Bu soru, mutasyonların etkilerinin neden özellikle mikroorganizmalarda (özellikle bakterilerde) daha kolay incelenebildiğini sorgulayan bir biyoteknoloji ve genetik sorusudur.
Mutasyonlar, DNA diziliminde meydana gelen değişikliklerdir. Bu değişikliklerin etkilerini görmek için bir nesilde mutasyonun oluşması, sonra da bu neslin çoğalması ve gözlenmesi gerekir. Bakteriler gibi mikroorganizmalar, çok hızlı ürerler (örneğin E. coli her 20 dakikada bir bölünebilir). Bu yüzden mutasyonlar kısa sürede çoğalıp gözlemlenebilir hale gelir.
🔍 Şık Analizi:
A) ❌ Gen sayısının az olması, mutasyonun etkisini anlamayı kolaylaştırabilir ama en temel neden bu değildir.
B) ❌ DNA'nın halkasal olması, genetik yapı hakkında bilgi verir ama mutasyonların takibini kolaylaştıran asıl neden değildir.
C) ✅ Doğru → Hızlı üreme = daha çok nesil = daha çok gözlem şansı → Mutasyonun etkisi kısa sürede fark edilir. ✔️ Bu doğrudan mutasyon takibini kolaylaştırır.
D) ❌ Plazmitler genetik mühendisliğinde faydalıdır ama mutasyon takibiyle doğrudan ilgili değildir.
E) ❌ Bu doğru olabilir ama mutasyonun etkisini gözlemleme kolaylığıyla ilgisi yoktur.
Bir canlının gözlenen özellikleri, kalıtım ve çevrenin etkileşiminin ürünüdür.
Kalıtsal yapıları (genotipleri) aynı olan kıvrık kanatlı sirke sinekleriyle yapılan;
I. 25 oC sıcaklıktaki kıvrık kanatlı sirke sineklerinden kıvrık kanatlı yavruların oluşması
II. 16 oC sıcaklıkta yaşatılan kıvrık kanatlı sirke sineklerinin yavrularının düz kanatlı olması
III. Düz kanatlı bireyden oluşan larvaların, 25 oC'de yetiştirilince kıvrık kanatlı, 16 oC'de yetiştirilince düz kanatlı olması
Deneylerinden hangileri, bu yargıyı desteklemek için kullanılabilir?
A. Yalnız IDoğru Cevap İçin Tıklayınız...
Doğru Cevap: E
Açıklaması:
📘 Konu Hakkında Kısa Bilgi: Bu soru, modifikasyon – çevre ve kalıtım etkileşimi – genetik ifadelerin çevreye bağlı değişimi konularını içeren bir yorum ve analiz sorusudur. Genotip (kalıtsal yapı) bir canlının sahip olduğu genetik yapıdır. Ancak bu genler çevre koşullarına göre farklı şekilde ifade edilebilir (fenotip). → Buna modifikasyon denir. Bu nedenle aynı genotipe sahip bireyler, farklı çevresel koşullarda farklı fenotiplerle karşımıza çıkabilir.
🔍 Öncül Analizi:
I. ❌ Bu ifade, çevresel bir değişim örneği değil. → Kalıtımın kendisini gösterdiği durumdur. → Sabit bir çevre + beklenen kalıtımsal sonuç → çevre etkisi gözlenmiyor.
II. ✅ Bu, çevre etkisinin gözlendiği durumdur. → Aynı genotipe sahip bireyler farklı çevrede farklı fenotip geliştirmiş. → Bu bir modifikasyon örneğidir.
III. ✅ Bu da çevrenin fenotipe etkisini gösteren deneysel bir durumdur. → Genotip aynı fakat çevreye göre fenotip değişiyor. ✔️ Bu da genetik + çevre etkileşimini destekler.
İnsanlarda genetik çeşitliliğin oluşmasına neden olan;
I. Kromozomda bir genin koparak kaybolması
II. Homolog olmayan iki kromozom arasında genlerin yer değiştirmesi
III. DNA dizilerinden A-T nükleotit çiftinin G-S'ye dönüşmesi
IV. Homolog kromozomların kardeş olmayan kromatitleri arasında parça değişimi olması
Olaylarından hangileri anormallik olarak kabul edilmez?
A. Yalnız IIDoğru Cevap İçin Tıklayınız...
Doğru Cevap: I, III ve IV
Açıklaması:
📘 Konu Hakkında Kısa Bilgi: Bu soru, genetik çeşitlilik ve genetik anormallikler arasındaki farkı ölçen bir evrimsel genetik bilgisi sorusudur. Genetik çeşitlilik, tür içindeki bireyler arasında kalıtsal farklılıkların bulunmasıdır. Bazı olaylar doğal ve düzenli şekilde gerçekleşir ve bu çeşitliliğe katkı sağlar. Bazı olaylar ise DNA’ya zarar vererek ya da yapısını bozarak anormallik (mutasyon, kromozom bozukluğu) sayılır.
🔍 Öncül Analizi:
I. Kromozomda bir genin koparak kaybolması ❌ Anormalliktir → Bu bir delesyondur. → Geni kaybetmek, hastalıklara neden olabilir. ✔️ Genetik çeşitliliğe katkıdan çok, zararlıdır.
II. Homolog olmayan iki kromozom arasında genlerin yer değiştirmesi ❌ Anormalliktir → Bu durum translokasyon olarak adlandırılır. → Genler uygun olmayan yerlere geçebilir. → Bazı durumlarda sessiz olabilir, ama genellikle anormal kabul edilir.
III. DNA dizilerinden A-T çiftinin G-S'ye dönüşmesi ❌ Anormalliktir → Bu bir nokta mutasyonudur. → Gende değişikliğe yol açabilir. → Genetik çeşitliliğe neden olabilir ama yine de mutasyon = anormallik sınıfındadır.
IV. Homolog kromozomların kardeş olmayan kromatitleri arasında parça değişimi olması ✅ Normaldir → Bu olaya krossing-over (parça değişimi) denir. → Mayoz I sırasında doğal olarak gerçekleşir. → Genetik çeşitliliğin en önemli doğal mekanizmasıdır. ✔️ Anormallik değildir.
Aşağıdaki canlılardan hangisinde somatik hücrede oluşan bir mutasyonun yavru hücrelere aktarılma ihtimali yoktur?
A. Kavak ağacıDoğru Cevap İçin Tıklayınız...
Doğru Cevap: E
Açıklaması:
📘 Konu Hakkında Kısa Bilgi: Bu soru, somatik (vücut) hücrelerinde oluşan mutasyonların kalıtsal aktarımı ile ilgili temel bir kavrayışı ölçen bir kavram bilgisi ve yorum sorusudur. Öğrencinin üreme biçimlerine göre kalıtsal aktarım farkını anlamasını ölçer. Somatik mutasyon, vücut hücrelerinde (üreme hücresi dışındaki hücrelerde) meydana gelen mutasyonlardır. Kalıtsal değildir, çünkü üreme hücrelerine aktarılmazlar. Ancak bazı canlılarda, yeni bireyler vücut hücrelerinden meydana geldiği için bu mutasyonlar dolaylı yoldan yavru hücrelere geçebilir.
Bu olay özellikle: Vejetatif üreyen bitkilerde (örneğin: kavak ağacı), Rejenerasyonla çoğalan canlılarda (örneğin: deniz yıldızı, yassı solucan), Bölünme ile üreyen bir hücrelilerde (örneğin: paramesyum) mümkündür.
🔍 Şık Analizi:
A) Kavak ağacı ✅ → Vejetatif (eşeysiz) üreme ile çoğalabilir. → Somatik mutasyon, yeni bitkiye aktarılabilir.
B) Bir hücreli paramesyum ✅ → Hücre bölünmesi ile çoğalır. → Tüm yapı hücre olduğu için, mutasyon doğrudan yavruya geçer.
C) Deniz yıldızı ✅ → Rejenerasyonla çoğalabilir (kol kopmasıyla yeni birey oluşabilir). → Mutasyon varsa yeni bireye aktarılabilir.
D) Yassı solucan ✅ → Rejenerasyon yeteneği yüksektir. → Vücut hücrelerinden yeni birey oluşabilir → mutasyon aktarılabilir.
E) Kurbağa ❌ → Doğru cevap. → Eşeyli üreyen, gelişmiş bir hayvandır. → Üreme hücreleri dışındaki (somatik) mutasyonlar nesle aktarılmaz.
Farklı canlılara ait olan aşağıdaki özelliklerden hangisi modifikasyona örnek olarak gösterilemez?
A. Spor yapan bir bireyin kaslarının gelişmesiDoğru Cevap İçin Tıklayınız...
Doğru Cevap: C
Açıklaması:
📘 Konu Hakkında Kısa Bilgi: Bu soru, modifikasyon (kalıtsal olmayan değişiklikler) konusunu ölçen bir bilgi ve kavram ayırt etme sorusudur. Modifikasyon, çevre koşullarının etkisiyle canlıların dış görünüşlerinde (fenotiplerinde) ortaya çıkan kalıtsal olmayan değişikliklerdir. Modifikasyonlar gen yapısını değiştirmez, bu yüzden döl yolu ile aktarılamazlar. Genellikle spor, beslenme, ışık, sıcaklık gibi çevresel faktörlerle ilişkilidir. Refleksif ya da genetik programlı davranışlar modifikasyon sayılmaz.
🔍 Şık Analizi:
A) ✅ Modifikasyondur. → Spor, çevresel bir faktördür. → Kas gelişimi genetik değil çevresel etkidir. → Kalıtsal değildir.
B) ✅ Modifikasyondur. → Dış baskı ile gelişim şekillendirilmiş. → Genetik değil, fiziksel çevresel müdahale.
C) ❌ Modifikasyon değildir. → Bu geçici bir adaptif davranıştır, refleks gibidir. → Genetik olarak kontrol edilen anlık pigment değişimidir. → Kalıcı bir fenotip değişimi değildir. ✔️ Bu yüzden modifikasyon sayılmaz.
D) ✅ Modifikasyondur. → Çevresel ve fiziksel müdahale ile oluşmuş. → Genetik yapıyı değiştirmez.
E) ✅ Modifikasyondur. → Sporla gelişen fiziksel yapı → çevresel etki → Kalıtsal değil.
Aşağıda verilenlerden hangisi, yapay seçilim sonucu meydana getirilmez?
A. Et verimi yüksek olan ineklerDoğru Cevap İçin Tıklayınız...
Doğru Cevap: D
Açıklaması:
📘 Konu Hakkında Kısa Bilgi: Bu soru, yapay seçilim (ıslah çalışmaları) konusunu ölçen bir bilgi ve ayırt etme sorusudur. Öğrencinin yapay seçilimin sınırlarını bilmesini ve diğer biyoteknolojik tekniklerle karıştırmamasını bekler. Yapay seçilim, insanlar tarafından bilinçli olarak istenen özelliklere sahip bireylerin seçilip üretilmesiyle, bu özelliklerin sonraki nesillere aktarılmasını sağlar. Amaç: Verim, dayanıklılık, görünüm gibi özellikleri geliştirmektir. Sadece hâlâ yaşayan türler üzerinde yapılabilir. Nesli tamamen tükenmiş (yok olmuş) türlerde, genetik materyal yoksa yapay seçilim uygulanamaz.
🔍 Şık Analizi:
A) ✅ → Et verimi yüksek bireyler seçilir → yapay seçilimle geliştirilir.
B) ✅ → İnsan eliyle seçilip üretilmiş verimli türlerdir.
C) ✅ → Tarımda hibritleme ve seleksiyon teknikleriyle yaygınlaştırılır.
D) ❌ → Doğru cevap. → Bu işlem yapay seçilimle yapılamaz çünkü üreme için canlı birey gerekir. → Genetik mühendisliği ya da klonlama gibi farklı bilimsel yollar gerekebilir.
E) ✅ → Bu da bir ıslah çalışmasıdır, yaygın uygulama alanı vardır.
Aşağıdaki grafikler, yıllık yağış ortalamalarında farklılıklar saptanan bir ekosistemde, bir bitki popülasyonunun K, L, M, N, P ve R varyasyonlarının 1, 2 ve 3.yıllardaki dağılımını göstermektedir.

Buna göre, aşağıdaki yargılardan hangisi yanlıştır?
(2006-Öğrenci Seçme Sınavı (ÖSS))
A. Popülasyonun devamlılığı, varyasyonların birey sayılarının aynı kalmasıyla sağlanmıştır.Doğru Cevap İçin Tıklayınız...
Doğru Cevap: A
Açıklaması:
📘 Konu Bilgisi: Bu soru, çevresel değişikliklerin (yağış miktarı) popülasyon içindeki varyasyonlara etkisini inceleyen bir grafik yorumlama ve doğal seçilim analizi sorusudur.
Varyasyon: Aynı tür içinde farklı özelliklere sahip bireylerdir (örneğin K, L, M... gibi).
Doğal seçilim: Çevresel koşullara en iyi uyum sağlayan varyasyonlar avantaj kazanır.
Grafiklerde farklı yıllarda yağış değişiyor, buna bağlı olarak da farklı varyasyonların birey sayısı değişiyor.
🔍 Şık Analizi:
A) ❌ Yanlış → Grafikte her yıl varyasyonların birey sayısı değişiyor. → K ve L varyasyonları 3. yıl tamamen elenmiş, P ve R gibi varyasyonlar artmış. ✔️ Popülasyonun devamı, uyum sağlayan varyasyonların artışıyla olur; sabitlik yoktur. 🔑 Bu şık yanlıştır. → Doğru cevap.
B) ✅ Doğru → Grafiklerde varyasyon eğrileri yağış miktarına bağlı olarak yer değiştiriyor. → Örneğin M, 1. yılda en çok bireye sahipken, 3. yılda azalmış.
C) ✅ Doğru → Tüm grafiklerde toplam birey sayısı (yaklaşık 12.000) korunmuş. → Yalnızca dağılım değişmiş.
D) ✅ Doğru → Her yıl farklı varyasyon öne çıkıyor. → Bu uyum farkını gösterir.
E) ✅ Doğru → K ve L gibi varyasyonlar, 3. yılda tamamen kaybolmuş. → Bu, doğal seçilimle elenmedir.
1950'li yıllarda bir bölgede, DDT gibi tarım ilaçlarının kullanılmaya başlamasından hemen sonra, tarım ürünlerinden yüksek verim alınmış ve ayrıca, bölgede yaygın olan sıtma hastalığı hemen hemen ortadan kalkmıştır. Ancak sonraki 20 yıl içinde bölgede tarım ilaçları giderek daha fazla kullanıldığı halde, tarım zararlıları ve sıtma hastalığı artmaya başlamıştır.
Kullanılan tarım ilaçları,
I. Tarım zararlılarının direnç kazanması
II. Yararlı böceklerin yok olması
III. Tatlısu balıkları ve kurbağaların azalması
Değişikliklerinden hangilerine neden olduğu için 20 yıl sonraki bu durum ortaya çıkmıştır?
(2020-YKS-Alan Yeterlilik Testleri (AYT))
A. Yalnız IDoğru Cevap İçin Tıklayınız...
Doğru Cevap: E
Açıklaması:
📘 Konu Hakkında Kısa Bilgi: Bu soru, çevresel etkilerin ekosistem üzerindeki uzun vadeli sonuçlarını ve doğal seçilimin insan etkisiyle nasıl tetiklenebileceğini değerlendiren bir ekoloji ve evrimsel biyoloji sorusudur.
DDT gibi tarım ilaçları başlangıçta zararlı böcekleri öldürerek başarı sağlar. Ancak zamanla bazı böcekler bu kimyasallara karşı genetik direnç geliştirir (doğal seçilim). Bu ilaçlar yalnızca zararlıları değil, yararlı böcekleri de öldürebilir. Ayrıca, çevreye karışan bu ilaçlar su ekosistemlerini kirletir, bu da balık ve kurbağa popülasyonlarında düşüşe yol açar.
🔍 Öncül Analizi:
I. ✅ Doğru → DDT'ye dirençli genlere sahip bireyler hayatta kalır, ürer → zamanla popülasyon dirençli hale gelir. ✔️ Doğal seçilimin sonucudur.
II. ✅ Doğru → Tarım ilaçları zararlı–yararlı ayrımı yapmaz. → Arılar, tozlaştırıcılar gibi ekolojik dengeyi sağlayan canlılar da etkilenir. ✔️ Zararlıların kontrolsüz çoğalmasına neden olabilir.
III. ✅ Doğru → İlaç kalıntıları suya karışır → biyoakümülasyon (besin zincirinde birikme) oluşur. → Kurbağalar ve balıklar gibi su canlıları zarar görür. ✔️ Ekosistem çökmesine katkı sağlar.
Aşağıdaki şekilde DNA'da meydana gelen bir mutasyon gösterilmiştir.

Bu mutasyon sonucunda aşağıdakilerden hangisi meydana gelmiştir?
A. Kromozom üzerindeki gen sayısında artmaDoğru Cevap İçin Tıklayınız...
Doğru Cevap: B
Açıklaması:
📘 Konu Hakkında Kısa Bilgi: Bu soru, bir gen düzeyindeki mutasyonu anlamaya yönelik bir DNA ve mutasyon sorusudur. DNA, nükleotitlerden oluşan bir moleküldür. Her nükleotit bir baz (A, T, G, S yani S = C), bir şeker ve bir fosfat içerir. Bir gendeki nükleotit sırası, o genin anlamını yani kodladığı bilgiyi belirler. Bu sıralamadaki küçük bir değişiklik bile genin işlevini bozabilir veya farklı bir ürün ortaya çıkmasına neden olabilir. Bu tür değişiklikler genellikle nokta mutasyonu olarak adlandırılır ve genetik hastalıklara ya da varyasyona yol açabilir.
🧬 Şekil Yorumu: Şekilde, radyasyon etkisiyle "Normal DNA" → "Mutant DNA" dönüşümü gösterilmiştir. Baz çiftlerinin yeri değişmiştir (örneğin bir yerde A-T varken, mutantta G-S olmuş). Bu değişim, doğrudan bir genin baz dizilimini etkilemiştir. Kromozom düzeyinde değil, nükleotit düzeyinde bir değişiklik vardır.
🔍 Şık Analizi:
A) ❌ Yanlış → Gen sayısı değişmemiş, sadece bir genin yapısı değişmiştir.
B) ✅ Doğru → Şekilde tam olarak bu gösteriliyor. → Mutasyon genin baz sırasını değiştirmiş. ✔️ Nokta mutasyonu örneğidir.
C) ❌ Yanlış → Bu bir kromozom mutasyonudur (inversiyon). → Şekilde gösterilen olay bireysel baz değişimidir.
D) ❌ Yanlış → Gen sayısı değişmemiştir, sadece bir genin içeriği değişmiştir.
E) ❌ Yanlış → Bu durum poliploidi veya kromozom mutasyonlarıyla olur. → Şekilde gösterilen olay sadece DNA'nın küçük bir kısmında geçerli.
Öğrencilerimizin TYT (Temel Yeterlilik Testi) ve AYT (Alan Yeterlilik Testi) gibi sınavlara hazırlanırken kullanabilecekleri bilgileri sunuyoruz. Biyoloji konularında güçlü bir temel oluşturmak ve sınav başarınızı artırmak için doğru adrestesiniz!
Hasanefendi - Ramazan Paşa Mah.1921 Sok.No:24/A Efeler-Aydın
destek@biyolojihikayesi.com
+90.555.608 59 45
©
Biyoloji Hikayesi.
All Rights Reserved. Designed by
Biyoloji Hikayesi
Distributed By:
Rolpa Bilişim Pazarlama Yönetim Sistemleri